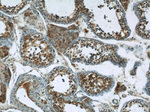
ARID4B Antibody in Immunohistochemistry (Paraffin) (IHC (P))

Search
Proteintech
ARID4B Polyclonal Antibody
{{$productOrderCtrl.translations['antibody.pdp.commerceCard.promotion.promotions']}}
{{$productOrderCtrl.translations['antibody.pdp.commerceCard.promotion.viewpromo']}}
{{$productOrderCtrl.translations['antibody.pdp.commerceCard.promotion.promocode']}}: {{promo.promoCode}} {{promo.promoTitle}} {{promo.promoDescription}}. {{$productOrderCtrl.translations['antibody.pdp.commerceCard.promotion.learnmore']}}
产品信息
24499-1-AP
种属反应
已发表种属
宿主/亚型
分类
类型
抗原
偶联物
形式
浓度
规格
纯化类型
保存液
内含物
保存条件
运输条件
产品详细信息
Immunogen sequence: MALPEKVVN KQCKECENVK EIKVKEENET EIKEIKMEEE RNIIPREEKP IEDEIERKEN IKPSLGSKKN LLESIPTHSD QEKEVNIKKP EDNENLDDKD DDTTRVDESL NIKVEAEEE (406-523 aa encoded by BC130418)
靶标信息
The exact function of C18orf25 remains unknown. There are two named isoforms.
仅用于科研。不用于诊断过程。未经明确授权不得转售。
生物信息学
蛋白别名: 180 kDa Sin3-associated polypeptide; ARID domain-containing protein 4B; AT rich interactive domain 4B (RBP1-like); AT-rich interactive domain-containing protein 4B; BCAA isoform I; breast cancer-associated antigen 1; Breast cancer-associated antigen BRCAA1; breast carcinoma-associated antigen; Histone deacetylase complex subunit SAP180; Rb-binding protein homolog; Retinoblastoma-binding protein 1-like 1; SAP180; Sin3-associated polypeptide p180; SIN3A-associated protein 180; unnamed protein product
基因别名: ARID4B; BCAA; BRCAA1; RBBP1L1; RBP1L1; SAP180
UniProt ID: (Human) Q4LE39
Entrez Gene ID: (Human) 51742